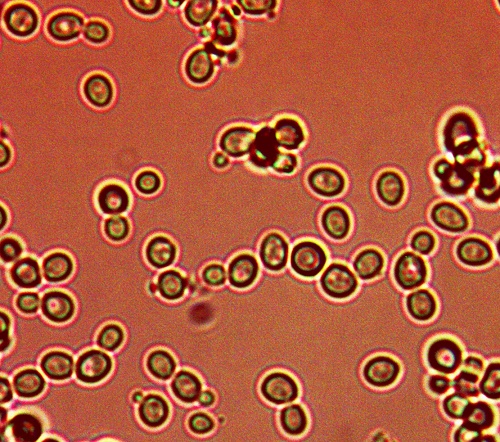

Cross Domain Bacteria (CDB) : Synthetic Blood & Hemoglobin
Clifford E Carnicom
Nov 06 2023
Testing information is available in the latter portion of this paper if you prefer to avoid an essay on our predicament.
Synthetic erythrocytes produced by CDB culture.
Original magnification 3200x.
A culture derived from the Cross Domain Bacteria (CDB) produces synthetic erythrocytes, or in common language, blood. The CDB are a synthetic, engineered xenobiotic life form that is deeply embedded into the history of Carnicom Institute (CI) research over a period of decades. Some readers will be familiar with the term “Morgellons”, a tragic “disease” that has afflicted (and caused the death of) many over these same decades; this condition evolved as a deep point of study within CI. The myopic term “Morgellons” minimized and marginalized the impact and suffering by many over these same decades, and the term has been woefully insufficient from its inception. This has been written and spoken of for many years by CI. CI has also made a continuous effort to trumpet the neglect and dismissal of those that have suffered and that continue to suffer. This pall remains fully in force, and the formal health and governmental infrastructures are fully culpable for these consequences.
We now have a new era of attention upon us, which I have coined as the “Covid Era”. Many of us view it as startlingly new and distinct, the likes of which have never been seen before. This is only partly true. Our attention span is short, and we may easily forget that which remains important.
It will eventually be seen that there is a completely consistent lineage of health damage, most especially to human blood, that traces back from more than 25 years to the present day. The origin of that damage is the Cross Domain Bacteria (CDB), nomenclature assigned out of necessity due to failure of participation from the scientific and professional communities.
That importance here is one of context. “Morgellons” never left us, and the “Covid Era” has not replaced it; is has only added to the complexity of health demise now upon us. I have written a series of papers over the last few months that discuss issues such as:
- A microbe (now understood to qualify as “synthetic”) that causes great damage and harm to human health (CDB).
- Proteins created by living organisms, and their importance in the understanding of disease.
- The necessity for culturing processes to be in place.
- Physical and biological damage to the blood from this same particular microbe (CDB).
- Phenomenal microscopic and biological observations, especially under the microscope and with cultures (some published, most not).
- Blood coagulation and clotting (the new kid on the block).
- Synthetic blood and fundamental scientific thresholds being crossed over on a sustained basis.
- The importance of the sciences of chemistry, biology and most professional disciplines to carve out a path of understanding to what remains ahead of us and unknown. Chemistry and biology to no end.
Most of these subjects have been under my pen for more than a couple of decades now. That includes the topics of even this present paper. So we may ask, what is different now? Why must yet another paper be written?
The reason is twofold. It is item six on the list above, combined with the advent of the “Covid Era“.
It is the assessment of this author that item six above is the most pressing concern before us. The health of the general population and environment is compromised in serious ways over decades now, and the source of that demise, at least in part, has been the focus of CI’s history and research. Many have died or are dying, more than need be, and most of us bear the ravages of compromised health for the same reasons. CI has done its best to tell that story.
The “Covid Era” and purported “vaccinations” have introduced another layer of complexity into the picture, and that is that even more people are dying now. In the current situation, it appears to be largely traceable to an increase in coagulation, clotting, and further demise of the blood. You will see that this same blood has been the dominant theme of the list of 8 items above for the last 25 years. Hence, the understanding of that FURTHER AND INCREASED RATE OF DEMISE of the blood seems to be a sensible priority to me. And so it shall be from the CI perspective. Teams of highest caliber professionals of ethics and conscience should have been dedicated to this and related problems decades ago.
_____________________________________________________________
The prevention of many of the most fundamental diseases of human history can be traced to an understanding of the proteins created by that disease, i.e., alterations they make to the human body. Interruption of the growth of those same proteins is the key to prevention in most cases (Alzheimer’s, Parkinson’s Disease, HIV, and Mad Cow Disease (BSE) are good examples of such quests). This requires smarts, knowledge, resources, work, and likely some good fortune along the way.
_____________________________________________________________
What this requires is specific understanding, and not a generalized milieu of postulations or speculations that become self-rotating. The lay public admittedly has restricted access to resources, tools and skills but we must put our best foot forward. CI is after the what and how of blood coagulation, clotting and demise as well as a means of disruption of that same end. CI does not regard the complications of the Covid Era as singular in nature. I have said before that no one is in a position to fight if they are sick. The sickness goes back for many years, its origin is determinable to a large extent, and it is now exacerbated to a more visible form.
Thank you for bearing with this parley; the rest of the paper should be easier.
_____________________________________________________________
The short of it is that the synthetic blood now under production through culture is confirmed to produce hemoglobin. This statement deepens the consequences before us.
The tests are conducted on the polymer-synthetic blood matrix material in three stages in a progressive fashion. These test are not conducted on human blood; they are performed on a culture of the CDB. There is no cause to equate the synthetic blood as an exact match for human blood. This synthetic biology produces erythrocytes which share important similarities with human blood; they are, however, a distinctly synthetic creation that is to be discovered with its own biological and genetic nature. The synthetic biology is known to share fundamental traits and characteristics with human biology.
The first test demonstrates the characteristic reaction of hydrogen peroxide that occurs when hydrogen peroxide is combined with blood. As many are aware, a vigorous bubble or foam reaction takes place. This test is actually for the detection of catalase, an antioxidant enzyme that is found in nearly all living creatures that are exposed to oxygen. We may note that the color of the cultured polymer matrix material is white as opposed to the red of blood. It is a useful start to the process.

Catalase test on CDB cultured synthetic polymer matrix material
that is observed to produce synthetic blood.
A bubbling/foaming reaction is observed.
The next test is what is known as a presumptive forensic test for the presence of hemoglobin, known as the Kastle-Meyer test. This test uses the combination of the acid-base color reagent indicator phenolphthalein with both blood and hydrogen peroxide. This test will produce a distinctly bright pinkish color in the presence of hemoglobin. This test is positive for hemoglobin at the presumptive level.

Positive presumptive Kastle-Myer forensic test for the presence of hemoglobin.
Test conducted on cultured CDB polymeric matrix.
The final test was conducted with a digital meter designed specifically for the detection of hemoglobin. This test uses an electrochemical reaction in a fashion akin to that designed for electronic glucose meters. This is a test method designed specifically for the presence of hemoglobin, and it is above and beyond the presumptive level. The magnitude of hemoglobin (i.e., concentration) should not be regarded with special attention due to many other factors that can affect that result. A positive measurable test result of any kind here is highly significant and confirming for the presence of hemoglobin.

Positive test for hemoglobin.
Test conducted on cultured CDB polymeric matrix material.
This is actually another case where work has been replicated. At some point we are in a position to determine when a discovery becomes important. In addition to the synthetic blood topics brought to light in the history of CI research (please see Cross-Domain Bacteria (CDB) Protein : The Fallout Emerges, Sep 2023), we will find previous hemoglobin tests of record. Additional confirmation was conducted approximately 15 years ago using a similar progressive style, please see BLOOD ISSUES INTENSIFY, (Apr 2009).
Once again, the difference in the case from that of previous work is that this stems from an isolated culturing process under more highly defined conditions, and the situation can be created at will. This is a critical difference that affects the progress of current and future work.
This stage of discovery and confirmation further cements the importance of a comprehensive understanding of the Cross Domain Bacteria (CDB). The proper and exact knowledge of this specific, identified, and cultured synthetic biology will provide many of the answers that we all require.
Clifford E Carnicom
Nov 06 2023
Born Clifford Bruce Stewart
Jan 19 1953